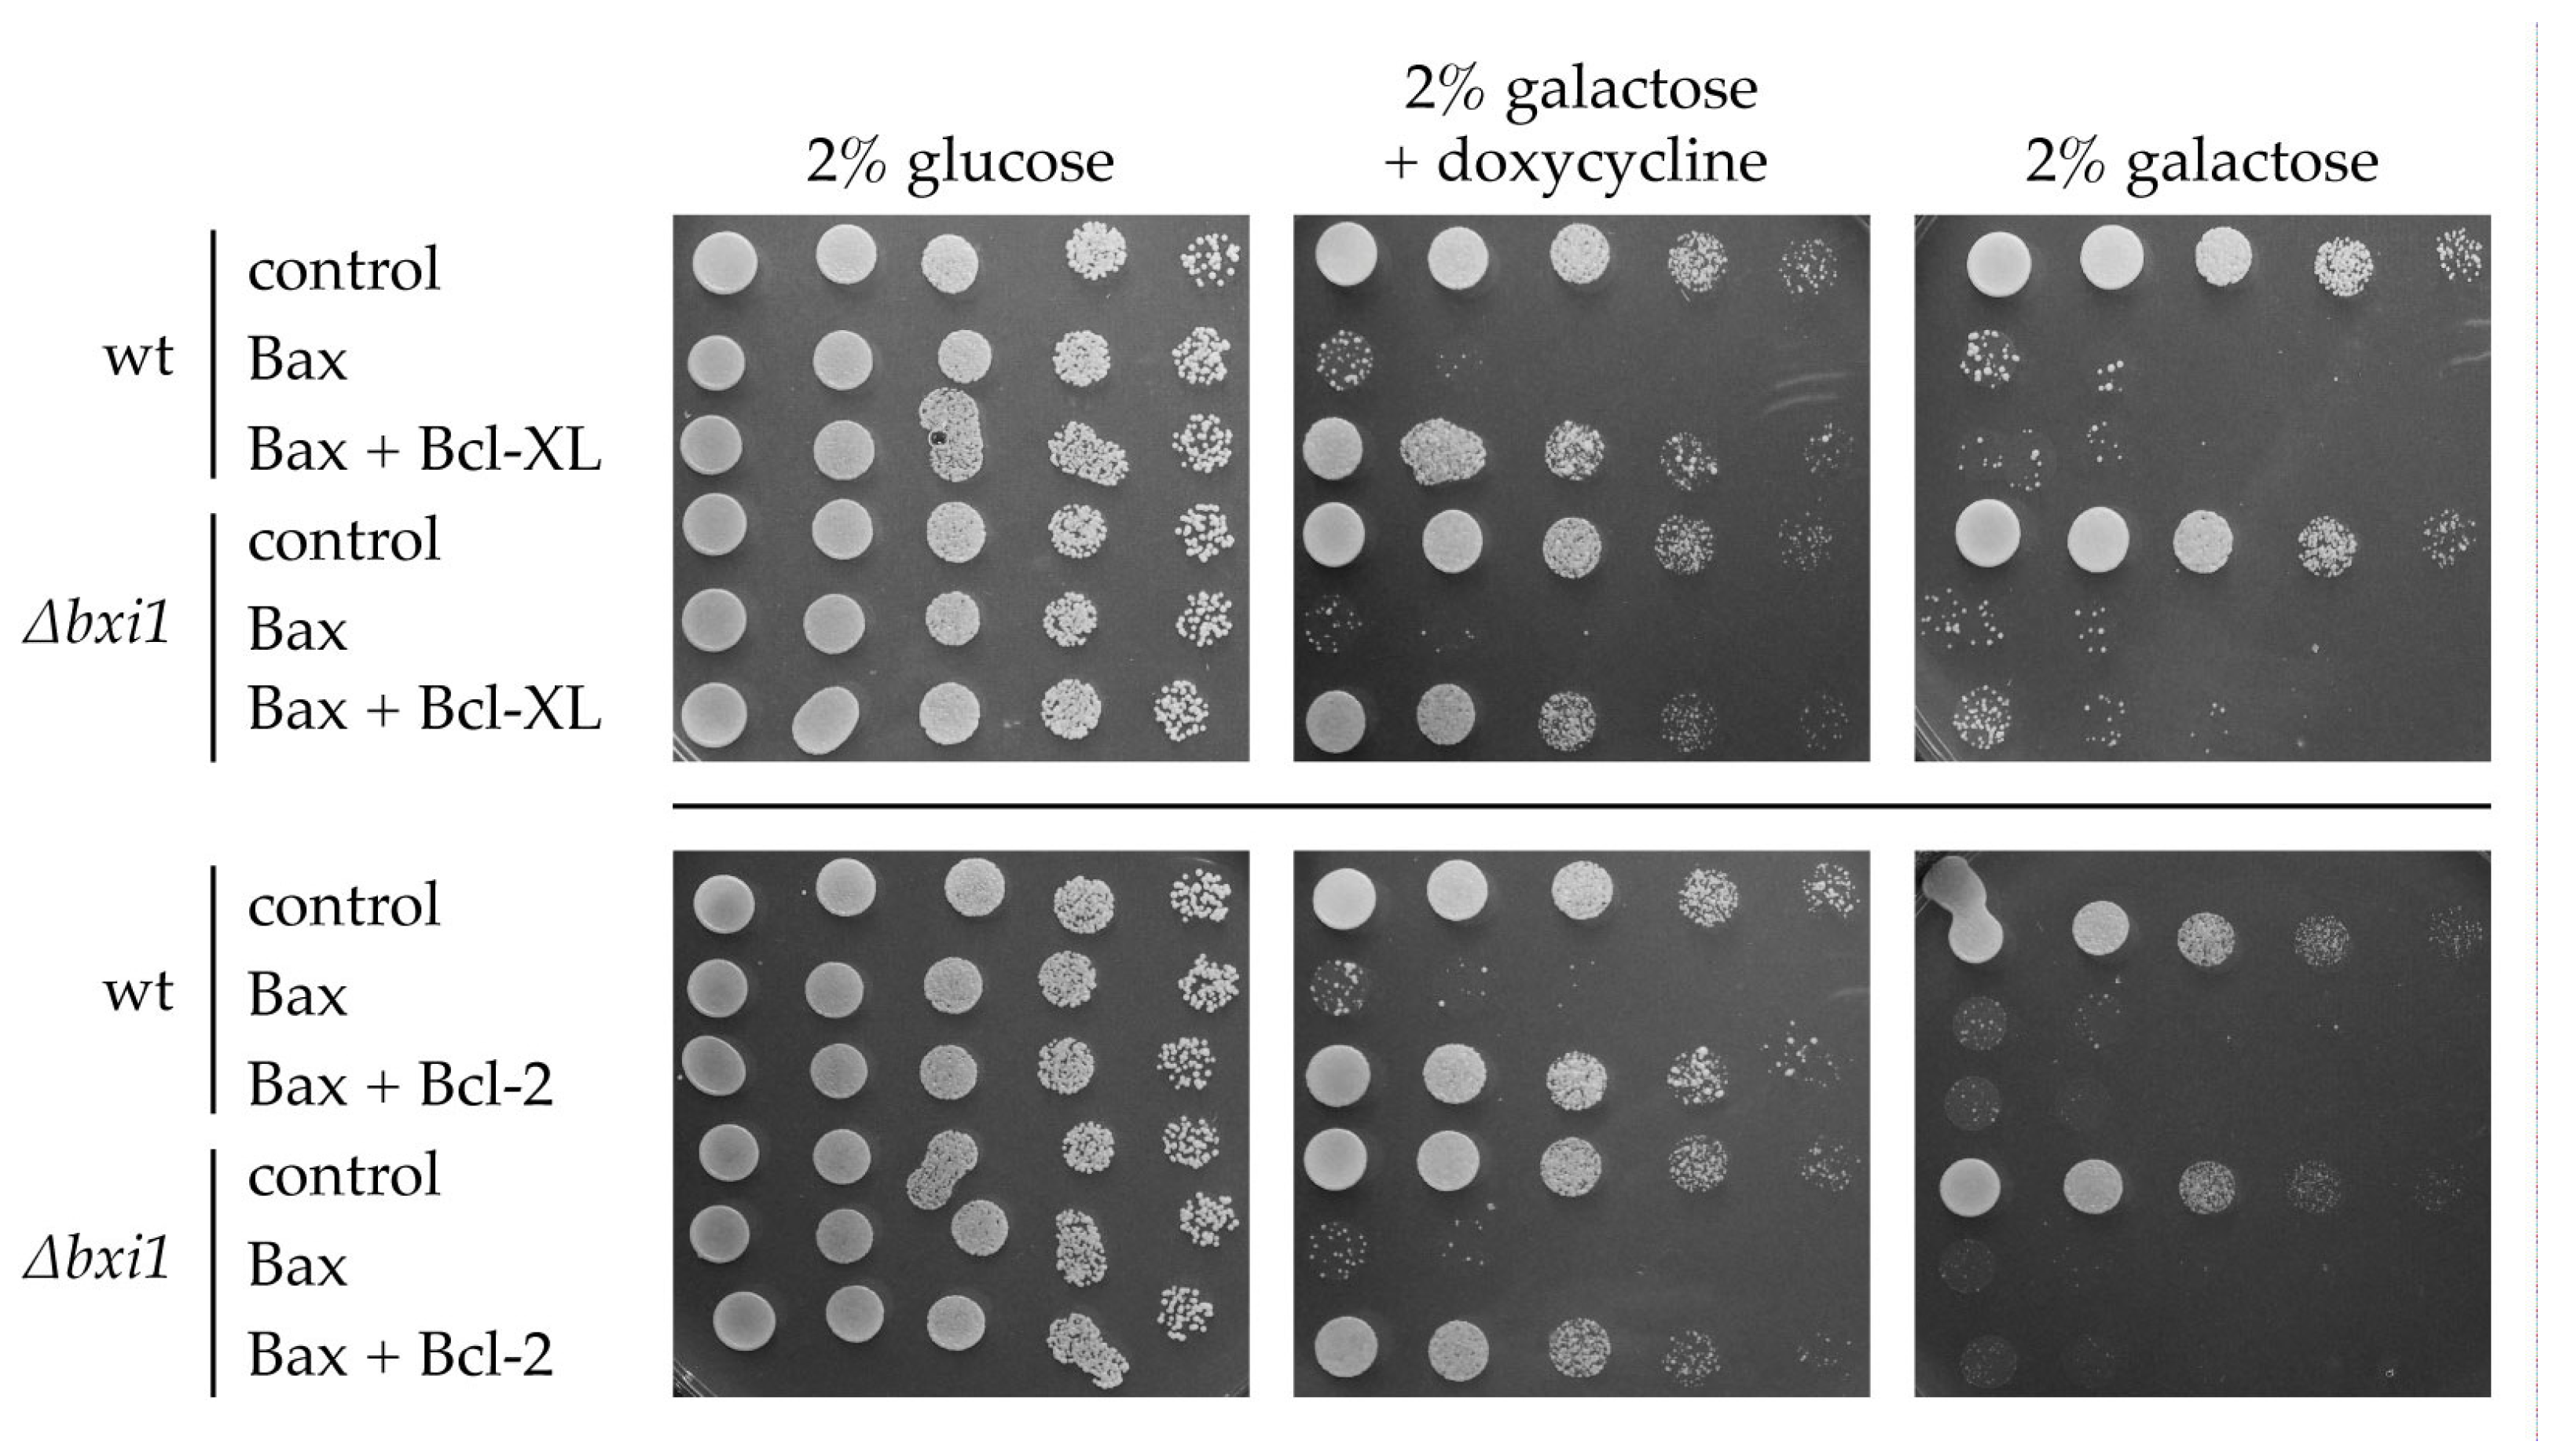
Ijms 24 12011 g002

Yeast Bax Inhibitor (Bxi1p/Ybh3p) Is Not Required for the Action of Bcl-2 Family Proteins on Cell Viability
Abstract
1. Introduction
2. Results
3. Discussion
4. Materials and Methods
4.1. Strains, Plasmids, and Growth Conditions
4.2. Viability Tests
5. Conclusions
Author Contributions
Funding
Acknowledgments
Conflicts of Interest
References
- Youle, R.J.; Strasser, A. The BCL-2 protein family: Opposing activities that mediate cell death. Nat. Rev. Mol. Cell Biol. 2008, 9, 47–59. [Google Scholar] [CrossRef] [PubMed]
- Aouacheria, A.; Rech de Laval, V.; Combet, C.; Hardwick, J.M. Evolution of Bcl-2 homology motifs: Homology versus homoplasy. Trends Cell Biol. 2013, 23, 103–111. [Google Scholar] [CrossRef] [PubMed]
- Moldoveanu, T.; Follis, A.V.; Kriwacki, R.W.; Green, D.R. Many players in BCL-2 family affairs. Trends Biochem. Sci. 2014, 39, 101–111. [Google Scholar] [CrossRef]
- Czabotar, P.E.; Garcia-Saez, A.J. Mechanisms of BCL-2 family proteins in mitochondrial apoptosis. Nat. Rev. Mol. Cell Biol. 2023, 1–17. [Google Scholar] [CrossRef] [PubMed]
- Carmona-Gutierrez, D.; Eisenberg, T.; Büttner, S.; Meisinger, C.; Kroemer, G.; Madeo, F. Apoptosis in yeast: Triggers, pathways, subroutines. Cell Death Differ. 2010, 17, 763–773. [Google Scholar] [CrossRef] [PubMed]
- Carmona-Gutierrez, D.; Bauer, M.A.; Zimmermann, A.; Aguilera, A.; Austriaco, N.; Ayscough, K.; Balzan, R.; Bar-Nun, S.; Barrientos, A.; Belenky, P.; et al. Guidelines and recommendations on yeast cell death nomenclature. Microb. Cell 2018, 5, 4–31. [Google Scholar] [CrossRef] [PubMed]
- Sato, T.; Hanada, M.; Bodrug, S.; Irie, S.; Iwama, N.; Boise, L.H.; Thompson, C.B.; Golemis, E.; Fong, L.; Wang, H.G.; et al. Interactions among members of the Bcl-2 protein family analyzed with a yeast two-hybrid system. Proc. Natl. Acad. Sci. USA 1994, 91, 9238–9242. [Google Scholar] [CrossRef]
- Zha, H.; Fisk, H.A.; Yaffe, M.P.; Mahajan, N.; Herman, B.; Reed, J.C. Structure-function comparisons of the proapoptotic protein Bax in yeast and mammalian cells. Mol. Cell Biol. 1996, 16, 6494–6508. [Google Scholar] [CrossRef]
- Polčic, P.; Forte, M. Response of yeast to the regulated expression of proteins in the Bcl-2 family. Biochem. J. 2003, 374, 393–402. [Google Scholar] [CrossRef]
- Juhásová, B.; Mentel, M.; Bhatia-Kiššová, I.; Zeman, I.; Kolarov, J.; Forte, M.; Polčic, P. BH3-only protein Bim inhibits activity of antiapoptotic members of Bcl-2 family when expressed in yeast. FEBS Lett. 2011, 585, 2709–2713. [Google Scholar] [CrossRef][Green Version]
- Gérecová, G.; Kopanicová, J.; Jaká, P.; Běhalová, L.; Juhásová, B.; Bhatia-Kiššová, I.; Forte, M.; Polčic, P.; Mentel, M. BH3-only proteins Noxa, Bik, Bmf, and Bid activate Bax and Bak indirectly when studied in yeast model. FEMS Yeast Res. 2013, 13, 747–754. [Google Scholar] [CrossRef]
- Polčic, P.; Mentel, M. Reconstituting the Mammalian Apoptotic Switch in Yeast. Genes 2020, 11, 145. [Google Scholar] [CrossRef] [PubMed]
- Manon, S. Yeast as a tool to decipher the molecular mechanisms underlying the functions of Bcl-2 family. Explor. Target. Antitumor Ther. 2022, 3, 128–148. [Google Scholar] [CrossRef]
- Xu, Q.; Reed, J.C. Bax inhibitor-1, a mammalian apoptosis suppressor identified by functional screening in yeast. Mol. Cell 1998, 1, 337–346. [Google Scholar] [CrossRef] [PubMed]
- Lisbona, F.; Rojas-Rivera, D.; Thielen, P.; Zamorano, S.; Todd, D.; Martinon, F.; Glavic, A.; Kress, C.; Lin, J.H.; Walter, P.; et al. BAX inhibitor-1 is a negative regulator of the ER stress sensor IRE1alpha. Mol. Cell 2009, 33, 679–691. [Google Scholar] [CrossRef]
- Lebeaupin, C.; Blanc, M.; Vallee, D.; Keller, H.; Bailly-Maitre, B. BAX inhibitor-1: Between stress and survival. FEBS J. 2020, 287, 1722–1736. [Google Scholar] [CrossRef] [PubMed]
- Carrara, G.; Saraiva, N.; Gubser, C.; Johnson, B.F.; Smith, G.L. Six-transmembrane topology for Golgi anti-apoptotic protein (GAAP) and Bax inhibitor 1 (BI-1) provides model for the transmembrane Bax inhibitor-containing motif (TMBIM) family. J. Biol. Chem. 2012, 287, 15896–15905. [Google Scholar] [CrossRef]
- Lisak, D.A.; Schacht, T.; Enders, V.; Habicht, J.; Kiviluoto, S.; Schneider, J.; Henke, N.; Bultynck, G.; Methner, A. The transmembrane Bax inhibitor motif (TMBIM) containing protein family: Tissue expression, intracellular localization and effects on the ER CA(2)(+)-filling state. Biochim. Biophys. Acta 2015, 1853, 2104–2114. [Google Scholar] [CrossRef]
- Rojas-Rivera, D.; Hetz, C. TMBIM protein family: Ancestral regulators of cell death. Oncogene 2015, 34, 269–280. [Google Scholar] [CrossRef]
- Chae, H.J.; Ke, N.; Kim, H.R.; Chen, S.; Godzik, A.; Dickman, M.; Reed, J.C. Evolutionarily conserved cytoprotection provided by Bax Inhibitor-1 homologs from animals, plants, and yeast. Gene 2003, 323, 101–113. [Google Scholar] [CrossRef]
- Cebulski, J.; Malouin, J.; Pinches, N.; Cascio, V.; Austriaco, N. Yeast Bax inhibitor, Bxi1p, is an ER-localized protein that links the unfolded protein response and programmed cell death in Saccharomyces cerevisiae. PLoS ONE 2011, 6, e20882. [Google Scholar] [CrossRef]
- Büttner, S.; Ruli, D.; Vögtle, F.N.; Galluzzi, L.; Moitzi, B.; Eisenberg, T.; Kepp, O.; Habernig, L.; Carmona-Gutierrez, D.; Rockenfeller, P.; et al. A yeast BH3-only protein mediates the mitochondrial pathway of apoptosis. EMBO J. 2011, 30, 2779–2792. [Google Scholar] [CrossRef] [PubMed]
- Sedlak, T.W.; Oltvai, Z.N.; Yang, E.; Wang, K.; Boise, L.H.; Thompson, C.B.; Korsmeyer, S.J. Multiple Bcl-2 family members demonstrate selective dimerizations with Bax. Proc. Natl. Acad. Sci. USA 1995, 92, 7834–7838. [Google Scholar] [CrossRef]
- Ottilie, S.; Diaz, J.L.; Chang, J.; Wilson, G.; Tuffo, K.M.; Weeks, S.; McConnell, M.; Wang, Y.; Oltersdorf, T.; Fritz, L.C. Structural and functional complementation of an inactive Bcl-2 mutant by Bax truncation. J. Biol. Chem. 1997, 272, 16955–16961. [Google Scholar] [CrossRef]
- Sattler, M.; Liang, H.; Nettesheim, D.; Meadows, R.P.; Harlan, J.E.; Eberstadt, M.; Yoon, H.S.; Shuker, S.B.; Chang, B.S.; Minn, A.J.; et al. Structure of Bcl-xL-Bak peptide complex: Recognition between regulators of apoptosis. Science 1997, 275, 983–986. [Google Scholar] [CrossRef] [PubMed]
- Petros, A.M.; Nettesheim, D.G.; Wang, Y.; Olejniczak, E.T.; Meadows, R.P.; Mack, J.; Swift, K.; Matayoshi, E.D.; Zhang, H.; Thompson, C.B.; et al. Rationale for Bcl-xL/Bad peptide complex formation from structure, mutagenesis, and biophysical studies. Protein Sci. 2000, 9, 2528–2534. [Google Scholar] [CrossRef]
- Liu, X.; Dai, S.; Zhu, Y.; Marrack, P.; Kappler, J.W. The structure of a Bcl-xL/Bim fragment complex: Implications for Bim function. Immunity 2003, 19, 341–352. [Google Scholar] [CrossRef] [PubMed]
- Suzuki, M.; Youle, R.J.; Tjandra, N. Structure of Bax: Coregulation of dimer formation and intracellular localization. Cell 2000, 103, 645–654. [Google Scholar] [CrossRef]
- Pavlov, E.V.; Priault, M.; Pietkiewicz, D.; Cheng, E.H.; Antonsson, B.; Manon, S.; Korsmeyer, S.J.; Mannella, C.A.; Kinnally, K.W. A novel, high conductance channel of mitochondria linked to apoptosis in mammalian cells and Bax expression in yeast. J. Cell Biol. 2001, 155, 725–731. [Google Scholar] [CrossRef]
- Gross, A.; Pilcher, K.; Blachly-Dyson, E.; Basso, E.; Jockel, J.; Bassik, M.C.; Korsmeyer, S.J.; Forte, M. Biochemical and genetic analysis of the mitochondrial response of yeast to BAX and BCL-X(L). Mol. Cell Biol. 2000, 20, 3125–3136. [Google Scholar] [CrossRef]
- Priault, M.; Camougrand, N.; Chaudhuri, B.; Schaeffer, J.; Manon, S. Comparison of the effects of bax-expression in yeast under fermentative and respiratory conditions: Investigation of the role of adenine nucleotides carrier and cytochrome c. FEBS Lett. 1999, 456, 232–238. [Google Scholar] [CrossRef]
- Kiššová, I.; Polčic, P.; Kempná, P.; Zeman, I.; Šabová, Ľ.; Kolarov, J. The cytotoxic action of Bax on yeast cells does not require mitochondrial ADP/ATP carrier but may be related to its import to the mitochondria. FEBS Lett. 2000, 471, 113–118. [Google Scholar] [CrossRef] [PubMed]
- Zara, V.; Dietmeier, K.; Palmisano, A.; Vozza, A.; Rassow, J.; Palmieri, F.; Pfanner, N. Yeast mitochondria lacking the phosphate carrier/p32 are blocked in phosphate transport but can import preproteins after regeneration of a membrane potential. Mol. Cell Biol. 1996, 16, 6524–6531. [Google Scholar] [CrossRef]
- Bharathi, V.; Girdhar, A.; Patel, B.K. Role of CNC1 gene in TDP-43 aggregation-induced oxidative stress-mediated cell death in S. cerevisiae model of ALS. Biochim. Biophys. Acta Mol. Cell Res. 2021, 1868, 118993. [Google Scholar] [CrossRef] [PubMed]
- Manzanares-Estreder, S.; Pascual-Ahuir, A.; Proft, M. Stress-Activated Degradation of Sphingolipids Regulates Mitochondrial Function and Cell Death in Yeast. Oxid. Med. Cell. Longev. 2017, 2017, 2708345. [Google Scholar] [CrossRef]
- Jones, N.K.; Arab, N.T.; Eid, R.; Gharib, N.; Sheibani, S.; Vali, H.; Khoury, C.; Murray, A.; Boucher, E.; Mandato, C.A.; et al. Human Thyroid Cancer-1 (TC-1) is a vertebrate specific oncogenic protein that protects against copper and pro-apoptotic genes in yeast. Microb. Cell 2015, 2, 247–255. [Google Scholar] [CrossRef]
- Chang, Y.; Bruni, R.; Kloss, B.; Assur, Z.; Kloppmann, E.; Rost, B.; Hendrickson, W.A.; Liu, Q. Structural basis for a pH-sensitive calcium leak across membranes. Science 2014, 344, 1131–1135. [Google Scholar] [CrossRef]
- Mullin, J.; Kalhorn, J.; Mello, N.; Raffa, A.; Strakosha, A.; Austriaco, O.P.N. Yeast Bax Inhibitor (Bxi1p/Ybh3p) is a Calcium Channel in E. coli. bioRxiv 2019, 722926. [Google Scholar] [CrossRef]
- Philippaert, K.; Roden, M.; Lisak, D.; Bueno, D.; Jelenik, T.; Radyushkin, K.; Schacht, T.; Mesuere, M.; Wullner, V.; Herrmann, A.K.; et al. Bax inhibitor-1 deficiency leads to obesity by increasing Ca(2+)-dependent insulin secretion. J. Mol. Med. 2020, 98, 849–862. [Google Scholar] [CrossRef]
- Bellí, G.; Garí, E.; Piedrafita, L.; Aldea, M.; Herrero, E. An activator/repressor dual system allows tight tetracycline-regulated gene expression in budding yeast. Nucleic Acids Res. 1998, 26, 942–947. [Google Scholar] [CrossRef]
- Schiestl, R.H.; Gietz, R.D. High efficiency transformation of intact yeast cells using single stranded nucleic acids as a carrier. Curr. Genet. 1989, 16, 339–346. [Google Scholar] [CrossRef]
- Mumberg, D.; Muller, R.; Funk, M. Regulatable promoters of Saccharomyces cerevisiae: Comparison of transcriptional activity and their use for heterologous expression. Nucleic Acids Res. 1994, 22, 5767–5768. [Google Scholar] [CrossRef] [PubMed]
- Juhásová, B.; Bhatia-Kiššová, I.; Polčicová, K.; Mentel, M.; Forte, M.; Polčic, P. Reconstitution of interactions of Murine gammaherpesvirus 68 M11 with Bcl-2 family proteins in yeast. Biochem. Biophys. Res. Commun. 2011, 407, 783–787. [Google Scholar] [CrossRef]
- Ludovico, P.; Sousa, M.J.; Silva, M.T.; Leao, C.L.; Corte-Real, M. Saccharomyces cerevisiae commits to a programmed cell death process in response to acetic acid. Microbiology 2001, 147, 2409–2415. [Google Scholar] [CrossRef] [PubMed]
- Madeo, F.; Fröhlich, E.; Ligr, M.; Grey, M.; Sigrist, S.J.; Wolf, D.H.; Fröhlich, K.U. Oxygen stress: A regulator of apoptosis in yeast. J. Cell Biol. 1999, 145, 757–767. [Google Scholar] [CrossRef] [PubMed]

Disclaimer/Publisher’s Note: The statements, opinions and data contained in all publications are solely those of the individual author(s) and contributor(s) and not of MDPI and/or the editor(s). MDPI and/or the editor(s) disclaim responsibility for any injury to people or property resulting from any ideas, methods, instructions or products referred to in the content. |
© 2023 by the authors. Licensee MDPI, Basel, Switzerland. This article is an open access article distributed under the terms and conditions of the Creative Commons Attribution (CC BY) license (https://creativecommons.org/licenses/by/4.0/).
Share and Cite
Mentel, M.; Illová, M.; Krajčovičová, V.; Kroupová, G.; Mannová, Z.; Chovančíková, P.; Polčic, P. Yeast Bax Inhibitor (Bxi1p/Ybh3p) Is Not Required for the Action of Bcl-2 Family Proteins on Cell Viability. Int. J. Mol. Sci. 2023, 24, 12011. https://doi.org/10.3390/ijms241512011
Mentel M, Illová M, Krajčovičová V, Kroupová G, Mannová Z, Chovančíková P, Polčic P. Yeast Bax Inhibitor (Bxi1p/Ybh3p) Is Not Required for the Action of Bcl-2 Family Proteins on Cell Viability. International Journal of Molecular Sciences. 2023; 24(15):12011. https://doi.org/10.3390/ijms241512011
Chicago/Turabian StyleMentel, Marek, Miroslava Illová, Veronika Krajčovičová, Gabriela Kroupová, Zuzana Mannová, Petra Chovančíková, and Peter Polčic. 2023. "Yeast Bax Inhibitor (Bxi1p/Ybh3p) Is Not Required for the Action of Bcl-2 Family Proteins on Cell Viability" International Journal of Molecular Sciences 24, no. 15: 12011. https://doi.org/10.3390/ijms241512011
APA StyleMentel, M., Illová, M., Krajčovičová, V., Kroupová, G., Mannová, Z., Chovančíková, P., & Polčic, P. (2023). Yeast Bax Inhibitor (Bxi1p/Ybh3p) Is Not Required for the Action of Bcl-2 Family Proteins on Cell Viability. International Journal of Molecular Sciences, 24(15), 12011. https://doi.org/10.3390/ijms241512011

